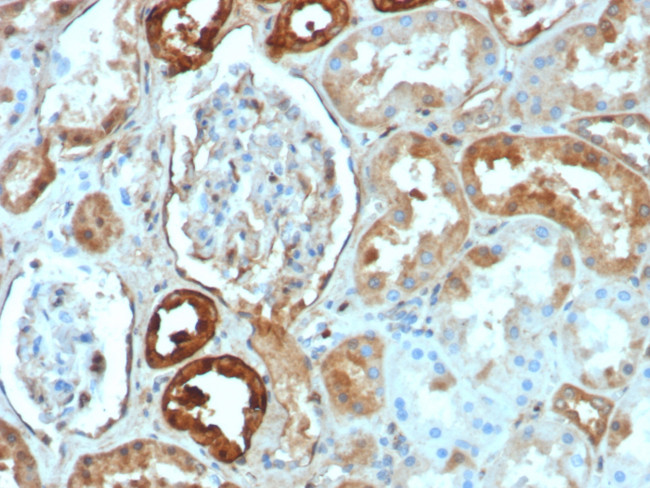
Calbindin 1 (CALB1) Antibody in Immunohistochemistry (Paraffin) (IHC (P))

Search
NeoBiotechnologies
Calbindin 1 (CALB1) Monoclonal Antibody (rCALB1/8499)
{{$productOrderCtrl.translations['antibody.pdp.commerceCard.promotion.promotions']}}
{{$productOrderCtrl.translations['antibody.pdp.commerceCard.promotion.viewpromo']}}
{{$productOrderCtrl.translations['antibody.pdp.commerceCard.promotion.promocode']}}: {{promo.promoCode}} {{promo.promoTitle}} {{promo.promoDescription}}. {{$productOrderCtrl.translations['antibody.pdp.commerceCard.promotion.learnmore']}}
产品信息
793-MSM7-P1ABX
种属反应
宿主/亚型
分类
类型
克隆号
抗原
偶联物
形式
浓度
纯化类型
保存液
内含物
保存条件
运输条件
靶标信息
Calbindin-D-28K (also termed vitamin D-dependent calcium-binding protein, or cholecalcin), is a highly conserved 28kDa calcium binding protein, with broad tissue distribution. It belongs, together with calmodulin, S-100, parvalbumin, troponin C and other proteins, to a family of low molecular weight calcium-binding proteins (CaBPs). These CaBPs have homologous primary structures, which contain conserved polypeptide folds of the EF-hand type for Ca2+ binding. Calbindin-D-28K is found predominantly in subpopulations of central and peripheral nervous system neurons, and in certain epithelial nervous system neurons, and in certain epithelial cells involved in Ca2+ transport such as distal tubular cells and cortical collecting tubules of the kidney, and in enteric neuroendocrine cells.
仅用于科研。不用于诊断过程。未经明确授权不得转售。
篇参考文献 (0)
生物信息学
蛋白别名: Calbindin; calbindin 1, (28kD); calbindin 1, 28kDa; Calbindin D28; D-28K; RTVL-H protein; Vitamin D-dependent calcium-binding protein, avian-type
基因别名: CAB27; CALB; CALB1; D-28K
UniProt ID: (Human) P05937
Entrez Gene ID: (Human) 793